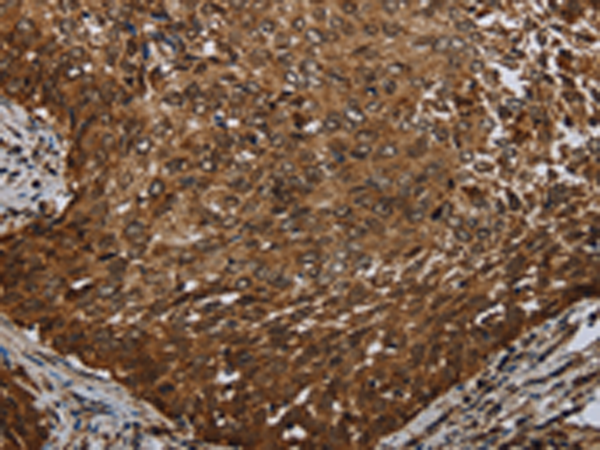

-
分类: 科研抗体货号: P11961别名: MPD; FP17780应用: IHC反应种属: Human, Mouse
-
分类: 科研抗体货号: P11963别名: DFNB2; MYU7A; NSRD2; USH1B; DFNA11; MYOVIIA应用: IHC反应种属: Human, Mouse
-
分类: 科研抗体货号: P11960别名: MTND3; ND3应用: IHC反应种属: Human
-
分类: 科研抗体货号: P11977别名: NFH应用: IHC反应种属: Human
-
分类: 科研抗体货号: P11959别名: MTND6; ND6应用: IHC反应种属: Human
-
分类: 科研抗体货号: P11975别名: NESG1; CCDC19应用: IHC反应种属: Human
-
分类: 科研抗体货号: P11957别名: MDM2BP应用: IHC反应种属: Human, Mouse
-
分类: 科研抗体货号: P11974别名: NEFA; HEL-S-109应用: IHC反应种属: Human
-
分类: 科研抗体货号: P11956别名: MASK; MST4应用: WB反应种属: Human, Mouse
-
分类: 科研抗体货号: P11973别名: CI-49应用: WB,IHC反应种属: Human, Mouse, Rat

鄂公网安备42018502007531号
鄂公网安备42018502007531号

